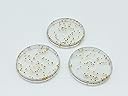
Thumbnail 3

We remain fully operational. Our teams are working around the clock to ensure your deliveries continue safely.
Servicios al cliente
Sobre nosotros
Copyright © 2025 Desertcart Holdings Limited

| Manufacturer | Medoore |
| Brand | Medoore |
| Item Weight | 3.98 ounces |
| Package Dimensions | 5.1 x 4.4 x 1.8 inches |
| Color | Gold |
| Material Type | Plastic |
| Sheet Size | A6 |
| Manufacturer Part Number | N-248 |
D**E
Not for HP classic
I bought these to create a happy planner but this disc do not fit. I used the HP classic hole puncher the pages do not turn using this discs so I opted to return them. They are nice and durable bummer that I wasn’t able to use them
W**K
Confetti Binder Rings for DIY Notebooks and Planners
I like the 50 Pcs 35mm Plastic Book Binding Discs as they are perfect for my DIY notebooks and planners. These discbound expansion discs are easy to use and provide a secure hold on my pages. The confetti design adds a fun touch to my creations, and the mushroom hole and loose leaf ring make it easy to add or remove pages. The size of the discs is just right for my needs, and the pack of 50 ensures I have plenty on hand for future projects.
C**E
Does not fit
The pages do not turn well and the little tabs that form the “stem” of the mushroom on my dividers don’t lie flat. They’re cute, but they don’t work. I am returning these.
T**E
Something off about the design. Pretty but not functional
I absolutely LOVE the look of these, and the price is fantastic. UNFORTUNATELY, it is a case of form over function. The pages just don't turn. They catch, and the only way I can utilize these now is to use them for materials I am more "archiving" than using regularly. It's a true bummer, because as I said, I really loved the sort of 50's/retro look of them.
S**S
These work well.
The rings are great looking with gold flecks in them. They fit nicely and are sturdy to use. My only complaint is that they make the paper stick a little and make it hard to turn the pages. I think with more use they will be one smoother.
J**D
Sad Discovery
Sturdy and cute. Unfortunately they didn’t work with my Happy Planner and the pages were too hard to turn.I was so disappointed with that.But they are really cute!
A**R
Too thick
These would have been great if they were thin enough to use with the hole punch they are meant for. They are too thick and you can’t turn your pages because they catch.
M**K
Excellent Quality and Fast Shipping!
These are excellent! Very pretty and also ver functional. I used them to create my teacher lesson planner for this year and they are perfect! Gast shiooing and excellent quality!
M**Y
No sirvió para mi perforadora de hongo que tengo :(
NO LO RECOMINEDO, NO LO COMPREN, quedaron las hojas muy apretadas, los discos son tal cual en la fotos y bastante grandes como para hacer una libreta de 200 hojas el problema es que no gira la hoja con facilidad quedaron apretadas, no lo recomiendo.
Trustpilot
Hace 3 semanas
Hace 3 semanas